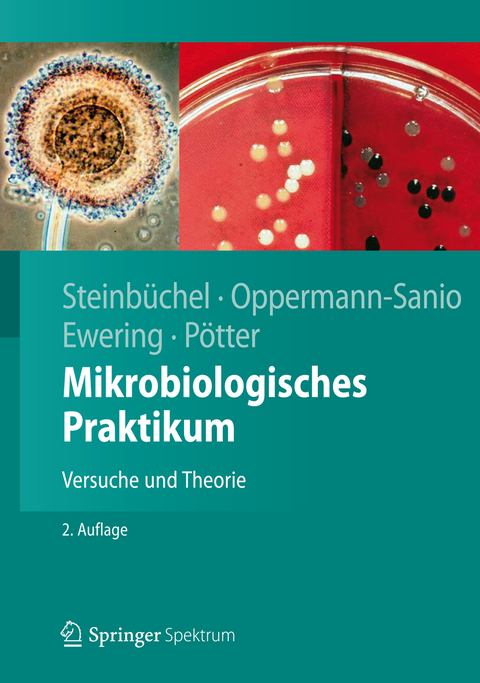
Mikrobiologisches Praktikum - Alexander Steinb&uuml;chel, Fred Bernd Oppermann-Sanio, Christian Ewering, Markus P&ouml;tter

Mikrobiologisches Praktikum
Springer (Verlag)
978-3-642-25150-4 (ISBN)
- Titel ist leider vergriffen;
keine Neuauflage - Artikel merken
Mikroorganismen und ihre Wirkungen sowie biotechnologische Produkte werden in einfachen und anschaulichen Versuchen sichtbar gemacht. Ein Leitfaden zeigt, welche Experimente für welche Zielgruppe geeignet sind, die jeweiligen theoretischen Grundlagen werden ausführlich dargestellt. Außerdem liefert der Band Anregungen für Exkursionen. Kontrollfragen am Schluss jedes Kapitels dienen der Prüfungsvorbereitung und Nachbereitung. In der Neuauflage sind alle Abbildungen farbig, die Inhalte wurden komplett überarbeitet und erweitert.
Alexander Steinbüchel ist Inhaber des Lehrstuhls für Mikrobiologie an der Universität Münster.
Fred-Bernd Oppermann-Sanio ist Akamdemischer Rat am Institut für Mikrobiologie der Universität Münster
Christian Ewering und Markus Pötter haben am Institut für Mikrobiologie der Universität Münster promoviert und sind inzwischen in der freien Wirtschaft tätig.
Einführung.- Überblick über die Mikroorganismen.- Vorschriften und Gestze im Zusammenhang mit mikrobiologischen Arbeiten.- Versuche.- Exkursionen und Demonstrationen von Mikroorganismen an natürlichen Standorten, in Umweltproben und in der Industrie.- Methoden.- Chemikalien, Nachweisreagenzien und Medien.- Modulare Zusammenstellung von Versuchen für unterschiedliche Zielgruppen.
Das Buch bietet also sowohl Lehrenden als auch Studierenden eine große Hilfestellung. Mancher Praktikumsleiter wird sich angeregt fühlen, die eigenen Versuche zu überarbeiten, neue Organismen ins Repertoire zu übernehmen oder den Praxisbezug der Versuche zu erweitern. Studierende finden Ideen und Hilfestellung für die Planung eigener Versuche und werden durch festigende und weiterführende Fragen zu jedem Versuch bei Protokollführung und Klausurvorbereitung unterstützt.
BIOSpektrum, Astrid Brandis-Heep, Juni 2013
Rückmeldung aus dem Dozentenversand von Rosa Margesin, Innsbruck:
Dieses Buch ist ein ideales Lehrbuch! Es enthält ein breites Spektrum von Übungen, deren Durchführung genau beschrieben und nachvollziehbar ist. Eine der Übungen habe ich bereits in einer meiner Lehrveranstaltungen erfolgreich durchgeführt.
Zu jeder Übung gibt es eine detaillierte Einleitung, sodass auch der theoretische Hintergrund stets abrufbar ist. Abbildungen in Farbe und Tabellen sind sorgsam ausgewählt und untermauern jede Übung. Somit kann ich dieses Buch nur empfehlen (10 Punkte auf einer 10-teiligen Skala), es ist meiner Meinung nach das beste derzeit erhältliche Werk zum Thema "Mikrobiologisches Praktikum".
Aus einer Rezension zur Vorauflage:
"Ein Buch, hervorragend geeignet für die Klausurvorbereitung, aber auch ein gutes Übungs- und Nachschlagewerk nicht nur für Biologen und Mediziner. ... ist gleichermaßen für alle Bereiche der Life Sciences und darüber hinaus interessant. ... Zahlreiche Versuche- einfach durchzuführen- unterstreichen den praktischen Beweis der Leistungen, die Mikroorganismen erbringen ..." (Carsten Hansen, in: Buchkatalog www.Buchkatalog.de, June/2011)
Aus einer Rezension zur Vorauflage:
Ein Buch, hervorragend geeignet für die Klausurvorbereitung, aber auch ein gutes Übungs- und Nachschlagewerk nicht nur für Biologen und Mediziner. ... ist gleichermaßen für alle Bereiche der Life Sciences und darüber hinaus interessant. ... Zahlreiche Versuche- einfach durchzuführen- unterstreichen den praktischen Beweis der Leistungen, die Mikroorganismen erbringen ... (Carsten Hansen, in: Buchkatalog www.Buchkatalog.de, June/2011)
| Erscheint lt. Verlag | 3.12.2012 |
|---|---|
| Reihe/Serie | Springer-Lehrbuch |
| Verlagsort | Berlin |
| Sprache | deutsch |
| Gewicht | 1145 g |
| Einbandart | gebunden |
| Themenwelt | Naturwissenschaften ► Biologie ► Mikrobiologie / Immunologie |
| Schlagworte | Abwasserkläranlage • Bierbrauerei • Biogasanlage • BioStoffV • Biostoffverordnung • Biotechnologie • Eukaryonten • Filtration • gentechnisch veränderte Mikroorganismen • Kompostwerk • Lösung • Mikrobiologie • Mikrobiologie; Handbuch/Lehrbuch • Mikrobiologisches Praktikum • mikrobiologische Versuche • Mikroorganismen • Nachweisreagenzien • Nährmedien • Nahrungskette • Pathogene Mikroorganismen • Praktikum, Mikrobiologie • Prokaryonten • Puffer • Silage • Sterilisation • Stoffkreislauf • Winzerei |
| ISBN-10 | 3-642-25150-1 / 3642251501 |
| ISBN-13 | 978-3-642-25150-4 / 9783642251504 |
| Zustand | Neuware |
| Informationen gemäß Produktsicherheitsverordnung (GPSR) | |
| Haben Sie eine Frage zum Produkt? |
aus dem Bereich